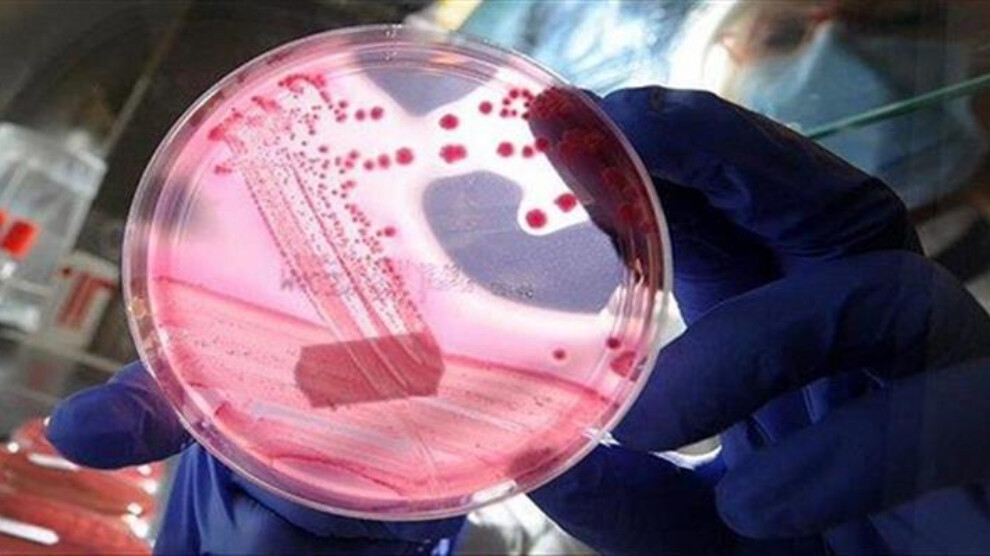

تای خوێنبەربوون بڵاوبووەتەوە و زیقار لە پلەی یەکەمدایە
نەخۆشی تای خوێنبەربوون بڵاوبووەتەوە و ڕاگەیەندراوی وەزارەتی تەندروستی عێراق هۆشداری لەو بارەیەوە دەدات.
ناوەندی هەواڵ
وەزارەتی تەندروستیی عێراق لە زاری وتەبێژەکەیەوە ئاشکرای کرد لە سەرەتای ئەمساڵەوە ٩٦ تووشبوو بە تای خوێنبەربوونیان تۆمار کردووە و لەو ژمارەیە ١٣ کەسیان گیانیان لەدەستداوە، نەخۆشییەکە لە پارێزگاکانی عێراقدا بڵاوبووەتەوە و زیقار بە ٢٨ تووشبوو لە پلەی یەکەمدایە.
بەپێی ئەو ڕیزبەندییەی کە وەزارەتی تەندروستی خستوویەتییە ڕوو، بەسرە ١٦ تووشبوو، میسان و نەجەف هەریەکەیان ٨ تووشبوو، موسەننا ٦ تووشبوو، بەغدا و رەسافە ٥ حاڵەتی تووشبووی تێدا تۆمار کراوە و لە پارێزگاکانی دیکە ٢ بۆ ٦ تووشبوو هەیە.
تای خوێنبەربوون، نەخۆشییەکە لە رێگەی زیندەوەرێکی بچوکەوە-گەنە، لە ئاژەڵەوە بۆ مرۆڤ دەگوازرێتەوە، لە زۆرینەی حاڵەتەکاندا نەخۆشییەکە لەسەر ئاژەڵ دەرناکەوێت، بەڵام کاریگەری لەسەر تەندروستی مرۆڤ دەكات و دەبێتە مەترسی بۆ سەر ژیانی تووشبووەکە.
